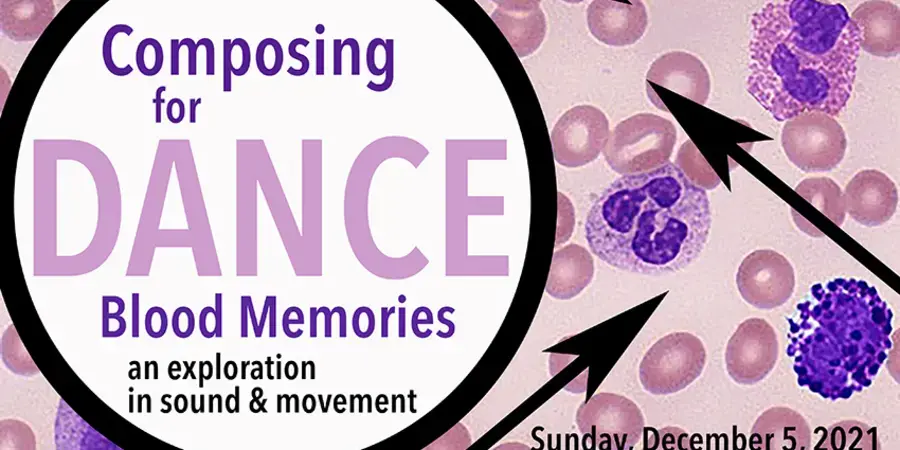
Composing for Dance

Composing for Dance
Sunday, Dec 5 2021,
4:00 PM - 5:00 PM,
VAPA Martha Hill Dance Theater
Contact:
Contact:
End-of-term performance by students in Michael Wimberly's Composing for Dance course.
Bennington College students, faculty and staff are exclusively invited to attend this event in person in Martha Hill Dance Theater. A video recording will stream publicly on Twitch and remain available for re-streaming for 14 days.